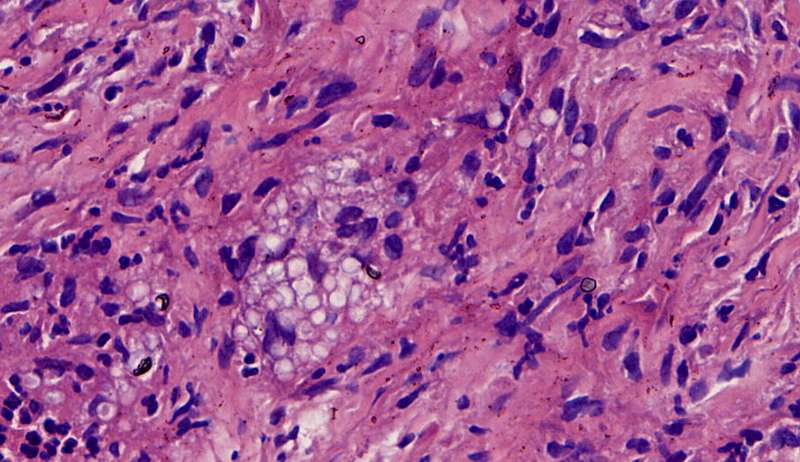
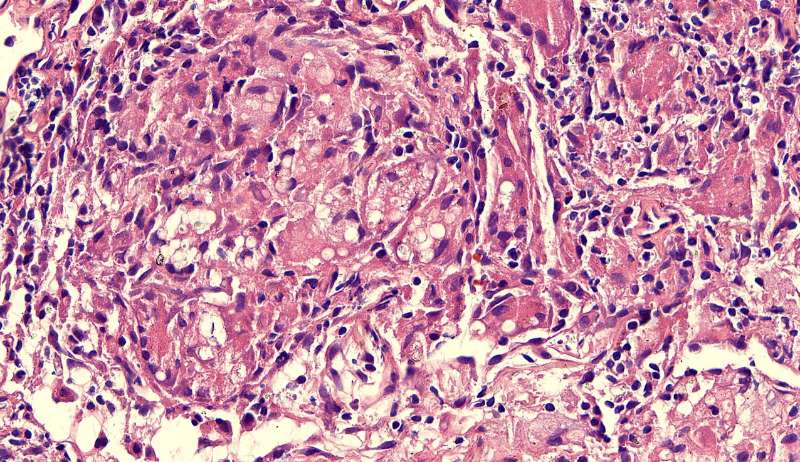
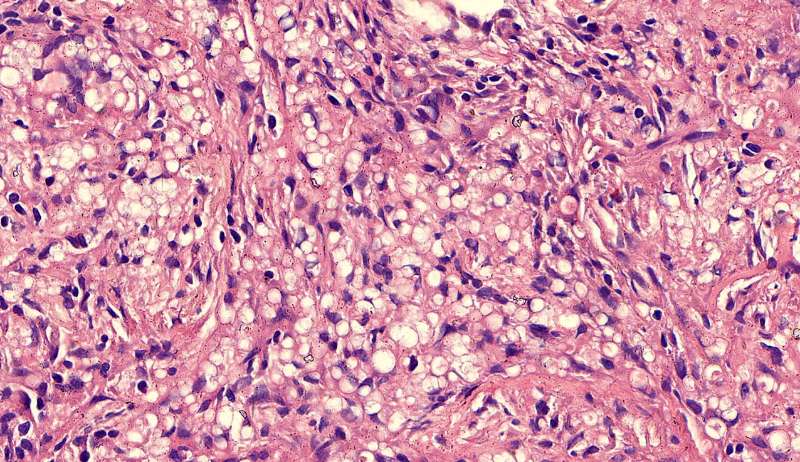
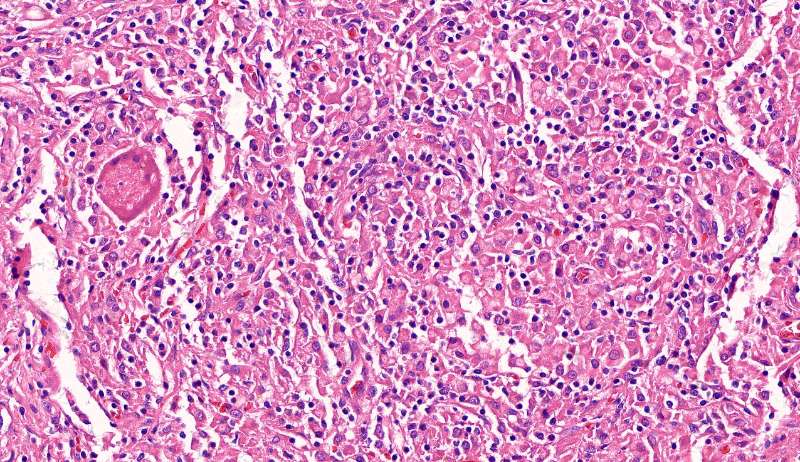
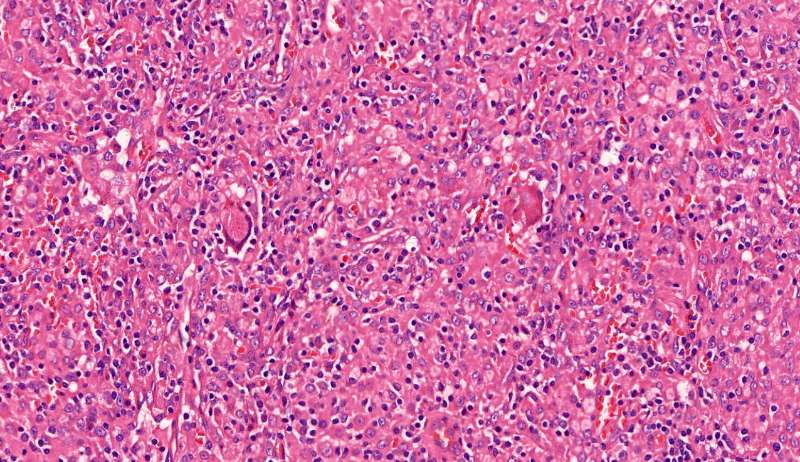
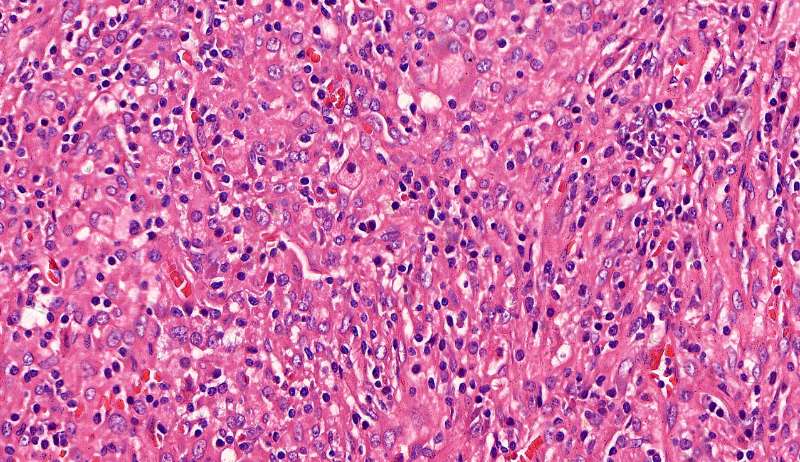

第七讲 肺部炎症(肿块)病理
曲霉菌

曲霉菌,一条条,呈分支状,分支的角度在45-75°,毛霉菌的分支角度接近直角,今天不讲毛霉菌,我们讲常见病。曲霉菌看上去比较清秀,均匀粗细,一般长在空腔里。


这个人的支气管腔有一大团曲霉,被冲掉了,扩张的支气管有炎症细胞浸润,还有支气管外侧,含铁血黄素沉积。

为什么有含铁血黄素呢? 曲霉菌容易使周围出现出血。太多含铁血黄素,吞不完 剩下一点曲霉菌,看看:


菌丝都快死了,隐约可见 这些红黑色点点是什么? 王:中性粒细胞,挺多的。这也是曲霉菌感染的一个特点。


刚才的曲霉菌是这里?王:是的,这里有残留菌丝 第二例曲霉




曲霉菌孢子很少见到,基本都是菌丝团,这里也是支气管扩张区,菌丝团偏黄褐色,也快死了。

蓝色圈圈是菌丝团?红色箭头是淋巴细胞?这是空腔边缘吗?王:是的,红箭头也可能是中性粒细胞。 红箭是支气管粘膜有炎症。


这里的菌丝形态清楚,下图小圆空的结构挺多,我理解为管状菌丝的断面
支气管扩张都有平滑肌增生吧?王:一般会有 王老师 ,这些是单纯HE染色还是有特殊染色?王:HE

有时曲霉菌团局部CT值很高,那大多是锰化 ABPA的粘液栓高密度,据说是草酸钙,我觉得也可能是锰化(待证实)

第三例曲霉菌:




3rd 在隔离肺的支气管里 也是在扩张的支气管内,有炎症细胞 紫红的可能是锰铁化,曲霉菌能吸收空气中的锰铁元素,在周边
隐球菌

结节状,周围型,宽基底,巨噬细胞多而且大,有纤维组织,所以经常有点收缩力

这些就是隐球菌,常被巨噬细胞吞噬,大多为多核巨噬细胞 隐球菌感染,在免疫力正常情况下,就是个肉芽肿 小白球,略显淡蓝色,这是荚膜的感觉
隐球菌在HE染色是小白球,隐隐的,球状的。在PAS染色是红色的小球,在六铵银染色是黑褐色的小球。


王:谁能说说这两幅?
戴畅:有散在的隐球菌及中性粒细胞 吕海容:有一些小泡泡是隐球菌,有纤维,有炎性细胞。

红圈是多核巨噬细胞,与结核有点区别,结核的langhans细胞核排列成大半圈,马蹄形

这里红色束状的是纤维,有胶原
第二例隐球菌





整体是个类圆形,边界模糊(有晕征的感觉),肉芽肿一般都这样 里面也能见到许多小白球,大小从3微米到20微米不等 红细胞直径5-6微米 普通小淋巴细胞直径5微米 这里淋巴细胞挺多 有许多淋巴细胞,成堆


多核巨噬细胞吞了许多隐球菌 经常是反包围的感觉



这三幅是周围区,也有巨噬细胞,单核的多 都在肺泡腔内 所以有ggo样密度 过一段时间,晕就消失,有时是消退,有时是实性区扩大,盖住磨玻璃晕 那也是吞噬的作用,常代表免疫力正常 就是警察多了把肺泡填了



前两幅是第一例
第二例也是类圆形结节状
第三例

许多小白球--隐球菌,不做PAS及六铵银特染也看得清 荚膜的感觉明显 第三例的CT


其他肉芽肿性炎


这个也有巨噬细胞,没有其他特别,就报了肉芽肿性炎 有疏松的纤维组织团


在脊柱旁 破坏力弱

收缩力弱,支气管血管完好。 再一例

巨噬细胞似乎也吞了点啥东西,PAS染色阴性 夹杂着许多淋巴细胞和单核巨噬细胞 有些胞浆淡,接近泡沫细胞 毛细血管有时较丰富 只能报肉芽肿性炎
再讲讲普通慢性炎症结节
通常有机化



这是个普通慢性炎症结节,有机化(纤维增生团)

最后发一例化脓性炎症

中性粒细胞很多,此处组织结构破坏

左侧液化,脓肿壁较规则平滑

周围的炎症机化区
破坏力在这里逐渐减弱

逐渐从中性粒细胞转为淋巴细胞为主
周边区:


肺泡内有渗出,逐渐吸收 机化是不是纤维细胞增多看的?王:是的
over
王老师,纤维增生团 和 masson小体是一个概念吗? 王:@李如雪 温州市中西医 差不多一个概念,MASSON 圆团状,纤维组织疏松,在肺泡腔内
任武科:哪位能再说一说中性,淋巴,巨噬细胞形态区别? 连晓峰:具体不知道。不过感觉在炎症组织中,可以猜一下。中性粒细胞一般体积较小,核较小,可见胞浆,核多不规则(分叶),核与核之间形态差别较明显,炎症组织可伴有液性无结构物质。淋巴细胞几乎看不见胞浆,核深染,各细胞的核形态相似,为圆形、椭圆、类圆形,常成堆存在(这个虽然不是鉴别点,但感觉有用,至少比投硬币靠谱)。巨噬细胞不会看,但感觉体积相对较大,核仁有时候看着均一深染,有时感觉有多个小颗粒,核里面白色区域较多,不知道什么原因,(不过如果看到多核细胞,直接认定多核巨噬细胞就好了,因为没有讲过其它的多核细胞)。综上,分不清就连看带猜
组织病理学和细胞学感觉不太是一回事,虽然有相关性。跟血液实验室交流过,他们看单个细胞可以很容易分出是什么细胞,但给他们看组织病理,他们看不懂。